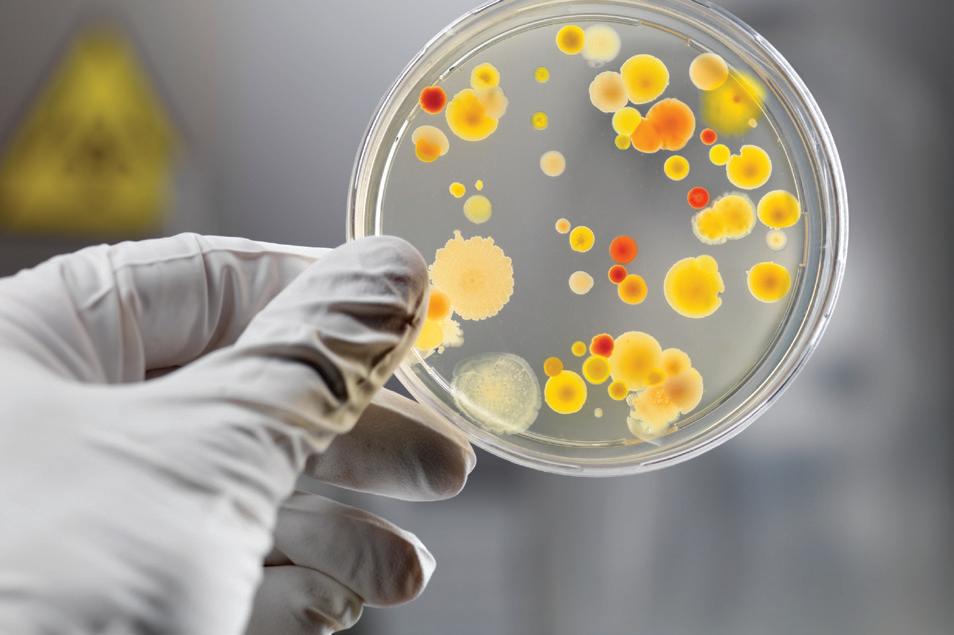

Sistemas de pisos para la industria farmacéutica


Experiencia consolidada, garantía para la industria farmacéutica.
Ferrocement® es una empresa especializada en el desarrollo de sistemas para pisos industriales sometidos a agresiones químicas y mecánicas, presentes en la industria farmacéutica.
Los sistemas de pisos industriales de Ferrocement® son elegidos por las compañías líderes del sector, tanto fabricantes primarios como secundarios de productos farmacéuticos. Sus soluciones se aplican en salas limpias, depósitos, corredores y laboratorios de investigación y desarrollo. Las firmas más exigentes eligen sistemas de pisos Ferrocement®
Seguridad para la producción y el consumidor
La presencia de microorganismos representa una seria amenaza para la producción. Por ello, los revestimientos antibióticos de Ferrocement® cumplen con las normas internacionales de salubridad e higiene, gracias a la incorporación de un aditivo biocida altamente efectivo, que protege las superficies frente a bacterias y microbios, inhibiendo su alojamiento y crecimiento. Entre los microorganismos controlados se incluyen: Escherichia coli, Salmonella, Pseudomonas y Staphylococcus.
Ejemplo de piso conductivo
Pacher 320® ECF
Espesor: 300 µ
Ferropur SL® Conductivo
Espesor: 3 mm
Ferropur HF® Conductivo
Espesor: 6 a 12 mm
Cintas Conductivas
Impridamp MB® Conductivo
Hormigón

por su alto rendimiento y su mayor vida útil, sumada a la variedad de colores y terminaciones disponibles, representan la mejor alternativa gracias a su alto estándar de calidad, brindando máxima tolerancia a agresiones químicas, resistencia mecánica y facilidad de limpieza y mantenimiento.
Sistemas conductivos
Los pisos industriales de Ferrocement® también pueden instalarse con propiedades conductivas, diseñadas para controlar la estática y reducir el riesgo de explosiones, además de prevenir fallas en equipos electrónicos sensibles.
La disipación de la carga eléctrica se realiza mediante la conexión del sistema de piso antiestático a tierra, asegurando máxima protección y confiabilidad en entornos críticos.



FERROPUR SL®
Revestimiento poliuretánico autonivelante para pisos sin juntas.
USOS
Ferropur SL® está recomendado para pisos industriales de alto tránsito que requieran superficies continuas, sin juntas, y con un alto estándar de higiene. Resiste agresiones químicas y mecánicas, y es elegido también por su gran valor arquitectónico.
Ideal para procesos secos o moderadamente húmedos.
BENEFICIOS
� Protege e impermeabiliza la superficie.
� Resistente a grasas, aceites y combustibles.
� Resistente a ácidos comunes, cáusticos y sales.
� Flexible, ideal para el tomado de juntas y fisuras.
� Fácil limpieza y mantenimiento.
� Contiene aditivo antibiótico.

Los sistemas Terrazo Ferropur TZ® y Pacher Monodec® se comercializan exclusivamente instalados con garantía integral de Ferrocement SA y Pisos y Revestimientos SA.
pyr.sa.com
FERROPUR TZ® & PACHER MONODEC®
Morteros poliméricos tipo terrazo de alta resistencia química y mecánica para pisos industriales.
USOS
Ferropur TZ® & Pacher Monodec® están recomendados para industrias que demanden máxima resistencia mecánica y química en sus pisos, así como una larga vida útil.
De fácil mantenimiento y gran impacto visual, resultan ideales para instalaciones con altos requerimientos de higiene, especialmente en la industria farmacéutica.
BENEFICIOS
� Alta resistencia a agresiones químicas.
� Alta resistencia mecánica y a la abrasión.
� Amplia variedad de terminaciones y colores.
� Muy fácil limpieza y mantenimiento.
� Resistente al lavado a alta presión y temperatura.
� Contiene aditivo antibiótico.
Pacher
& Top Pacher
Espesor: 200 µ
Ferropur SL® & Ferropur 70® Espesor: 2 a 3 mm

Ferropur TZ® o Pacher Monodec® Espesor: 8 a 12 mm
Habilitación al tránsito peatonal dentro de las 24 horas. Habilitación al tránsito peatonal dentro de las 24 horas.



FERROPUR MF®
Revestimiento poliuretánico de alta resistencia química y al desgaste para pisos industriales.
USOS
El uso de Ferropur MF® está recomendado para industrias con procesos húmedos o secos donde existan derrames químicos y se requiera resistencia mecánica y al desgaste moderados. Ideal para la industria farmacéutica en general.
BENEFICIOS
� Rápida habilitación.
� Resistente a agresiones químicas y a la abrasión.
� Amplia variedad de terminaciones y colores.
� Terminación lisa o anti deslizante.
� Fácil limpieza y mantenimiento.
� Contiene aditivo antibiótico.
Zócalo Pacher 700®
Top Ferropur GMF®
Espesor: 300 a 500 µ
Ferropur MF® & Ferropur 70®
Espesor: 4 a 6 mm
Impridamp MB®
Hormigón



GROUTER N28F®
Grout para capa terminal de muy alto tránsito para pisos industriales.
USOS
Grouter N28F® es un revestimiento de alta durabilidad, con excelente resistencia a la abrasión y a la compresión de cargas estáticas y dinámicas. Recomendado para depósitos y áreas de muy alto tránsito que requieran alcanzar los niveles de planitud (FF - Floor Flatness) y nivelación (FL - Floor Leveling) exigidos por los fabricantes de equipos de elevación de cargas.
BENEFICIOS
� Alta resistencia al desgaste y al impacto.
� Alta resistencia a la compresión de cargas puntuales.
� Se aplica sobre hormigón fresco logrando una superficie monolítica.
� Puede pulirse con apariencia de piso terrazo.
� Resistente a choques térmicos.
� Alta nivelación y planitud.
Ferrosil Litio® & Ferrosil Top® Protección de alto brillo
Mortero Grouter® Espesor: 20 mm
Hormigón

Usos recomendados.

CORREDORES Y DEPÓSITOS
Los morteros poliméricos de Ferrocement® están desarrollados para soportar el alto tránsito, así como también la resistencia a la compresión de cargas puntuales, para facilitar el tránsito de zorras, apiladoras uotros elementos.
Los morteros se pueden pulir dando una apariencia de piso terrazo, liso y uniforme.

FÁCIL LIMPIEZA Y MANTENIMIENTO
Además de contar con un aditivo antibiótico en su matriz, los revestimientos de Ferrocement® permiten realizar superficies libres de juntas. Los revestimientos pueden ser sometidos a rutinas de limpieza exigentes, incluso a altas temperaturas.
Algunas terminaciones de piso terrazo disponibles



ÁREAS DE PROCESOS
La línea de revestimientos de Ferrocement® tolera agresiones químicas resultantes de procesos de producción, ya sean en húmedo o en seco. Cada revestimiento está diseñado para cada proceso en particular.
Para más información, consulte la tabla comparativa de resistencias químicas.

VARIEDAD Y DURABILIDAD
Ferrocement® ofrece una amplia gama de terminaciones y acabados, desde superficies lisas, hasta fuertemente texturadas y resistentes al deslizamiento. Con apariencia monocolor (color pleno) o tipo terrazo. Los sistemas se adaptan al requerimiento de cada proyecto.




Calidad y respaldo
Ferrocement® desarrolla productos químicos y tecnologías innovadoras basados en una extensa experiencia y rigurosos ensayos técnicos, orientados a resolver las necesidades reales de profesionales, aplicadores y profesionales de la industria de la construcción.
Ferrocement® está certificada por IRAM – Instituto Argentino de Normalización y Certificación – en normas IRAM-ISO 9001-2008 en la gestión de la calidad para la producción y comercialización de productos cementíceos, poliméricos, aditivos minerales y orgánicos para la industria de la construcción.
Los sistemas Ferropur® y Pacher® de Ferrocement® incorporan un efectivo aditivo antibiótico que actúa como agente de inhibición antimicrobiana, conforme a la norma ISO 22196. Están especialmente diseñados para industrias con altos requerimientos de salubridad e higiene, y que deban cumplir con los estándares del sistema HACCP
Ante cualquier requerimiento técnico específico, es posible recibir asesoramiento de un Representante Técnico de Ferrocement®, quien podrá colaborar en la búsqueda de la solución adecuada para su proyecto. También puede encontrar más información en: ferrocement.com.ar
Oficinas comerciales y Planta industrial Av. Presidente Perón 9430 (B1714OMQ) Ituzaingó, Buenos Aires. Argentina. Tel (+54 11) 4621 2991
ferrocement.com.ar
